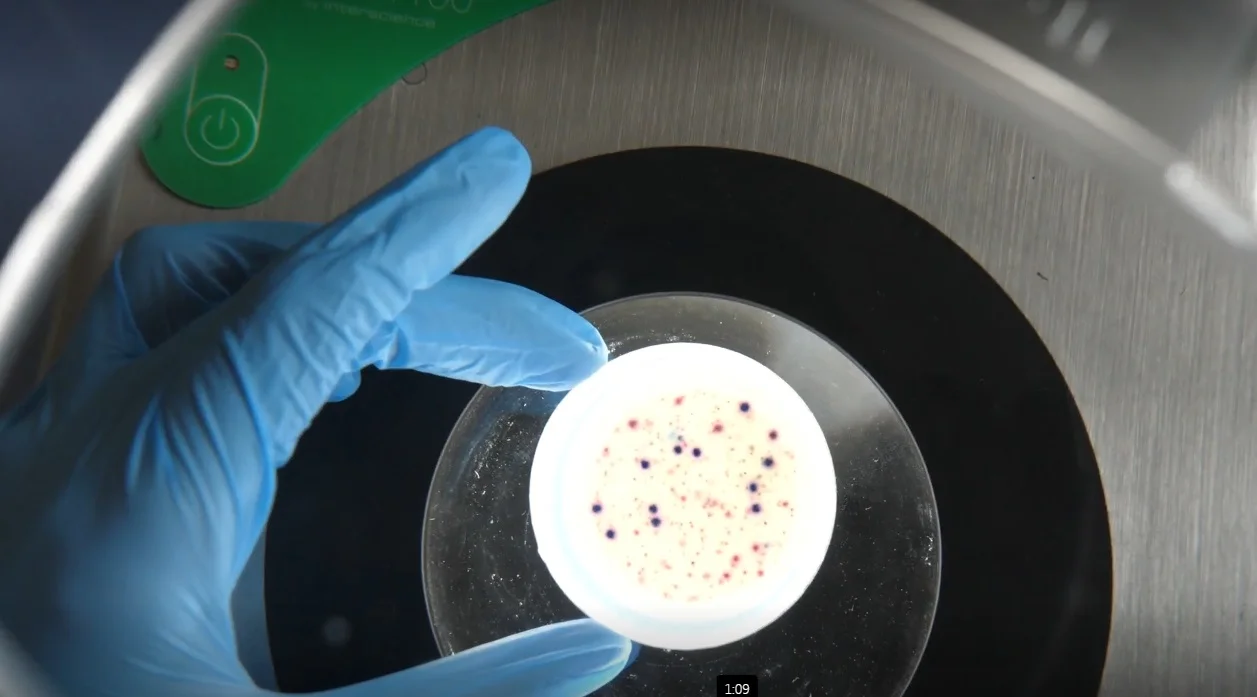

Samorząd Poznania - przy współpracy z naukowcami z Instytutu Chemii Bioorganicznej PAN i specjalistami z Grupy Aquanet - sprawdza, jak duża ilość materiału genetycznego koronawirusa znajduje się w ściekach.
- Badania koordynowane przez Wydział Gospodarki Komunalnej UMP są wynikiem porozumienia, podpisanego 18 października 2021 r. przez Miasto Poznań, Instytut Chemii Bioorganicznej PAN oraz spółki Aquanet Laboratorium i Aquanet S.A. - wyjaśnia Urząd Miasta Poznania.
Naukowcy badają ścieki w Poznaniu. Zatrważająca ilość koronawirusa
Z oficjalnych danych Ministerstwa Zdrowia wynika, że w pierwszych pięciu dniach marca w Poznaniu i powiecie poznańskim odnotowano 356 zakażeń SARS-CoV-2 - trzy razy więcej niż w pierwszym tygodniu lutego. W całym ubiegłym miesiącu zakażeń było 917.
- Ale to tylko oficjalne dane - w związku z tym, że wielu chorych nie przeprowadza testów, mogą nie odzwierciedlać rzeczywistości - twierdzą poznańscy urzędnicy.
Jako dowód wskazują wyniki monitoringu nieczystości.
Wynika z nich, że ilość materiału genetycznego koronawirusa jest największa od września 2021 roku. Kopii wirusa w ściekach jest, więc obecnie więcej niż na początku 2022 roku - czyli w czasie, gdy przez Polskę przechodziła największa fala zachorowań.
Magdalena Pietrusik-Adamska, szefowa Wydziału Zdrowia i Spraw Społecznych poznańskiego magistratu wyjaśnia, że do marca 2022 roku poziom materiału genetycznego koronawirusa w ściekach był porównywalny do oficjalnej, podawanej przez Ministerstwo Zdrowia liczby zachorowań.
- Wyniki były wiarygodne i spójne z oficjalnymi danymi. Jednak od kwietnia 2022 roku nie wszystkie zachorowania zgłaszane są do sanepidu. Nie ma już możliwości wykonania bezpłatnego testu antygenowego w aptece i punkcie wymazowym. Dlatego monitoring ścieków pozostaje najbardziej miarodajną metodą, która pozwala oszacować rzeczywistą liczbę zakażeń - tłumaczy Magdalena Pietrusik-Adamska.
Sprawdzana będzie też ilość grypy i wirusa RSV
Aktualnie miasto przygotowuje nową umowę na monitoring ścieków.
- Tym razem, badana ma być nie tylko ilość materiału genetycznego koronawirusa, ale również grypy i wirusa RSV, odpowiedzialnego za zakażenia dróg oddechowych i niebezpiecznego zwłaszcza dla dzieci - podaje urząd.

Komentarze (0)